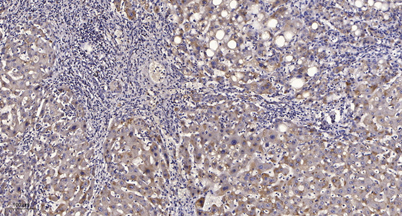

PFK-2 liv rabbit pAb
 One-click to copy product information
One-click to copy product information$148.00/50µL $248.00/100µL
| 50 µL | $148.00 |
| 100 µL | $248.00 |
Overview
| Product name: | PFK-2 liv rabbit pAb |
| Reactivity: | Human;Mouse;Rat |
| Alternative Names: | PFKFB1; F6PK; PFRX; 6-phosphofructo-2-kinase/fructose-2; 6-bisphosphatase 1; 6PF-2-K/Fru-2,6-P2ase 1; PFK/FBPase 1; 6PF-2-K/Fru-2,6-P2ase liver isozyme |
| Source: | Rabbit |
| Dilutions: | Western Blot: 1/500 - 1/2000. Immunohistochemistry: 1/100 - 1/300. ELISA: 1/5000. Not yet tested in other applications. |
| Immunogen: | The antiserum was produced against synthesized peptide derived from human PFKFB1. AA range:406-455 |
| Storage: | -20°C/1 year |
| Clonality: | Polyclonal |
| Isotype: | IgG |
| Concentration: | 1 mg/ml |
| Observed Band: | 58kD |
| GeneID: | 5207 |
| Human Swiss-Prot No: | P16118 |
| Cellular localization: | cytosol,6-phosphofructo-2-kinase/fructose-2,6-biphosphatase complex, |
| Background: | This gene encodes a member of the family of bifunctional 6-phosphofructo-2-kinase:fructose-2,6-biphosphatase enzymes. The enzyme forms a homodimer that catalyzes both the synthesis and degradation of fructose-2,6-biphosphate using independent catalytic domains. Fructose-2,6-biphosphate is an activator of the glycolysis pathway and an inhibitor of the gluconeogenesis pathway. Consequently, regulating fructose-2,6-biphosphate levels through the activity of this enzyme is thought to regulate glucose homeostasis. Multiple alternatively spliced transcript variants have been found for this gene. [provided by RefSeq, Nov 2012], |
-
 Western Blot analysis of various cells using PFK-2 liv Polyclonal Antibody
Western Blot analysis of various cells using PFK-2 liv Polyclonal Antibody -
 Western Blot analysis of Jurkat cells using PFK-2 liv Polyclonal Antibody
Western Blot analysis of Jurkat cells using PFK-2 liv Polyclonal Antibody -
 Western blot analysis of lysates from HUVEC cells and Jurkat cells, using PFKFB1 Antibody. The lane on the right is blocked with the synthesized peptide.
Western blot analysis of lysates from HUVEC cells and Jurkat cells, using PFKFB1 Antibody. The lane on the right is blocked with the synthesized peptide. -
Immunohistochemical analysis of paraffin-embedded human liver cancer. 1, Antibody was diluted at 1:200(4° overnight). 2, Tris-EDTA,pH9.0 was used for antigen retrieval. 3,Secondary antibody was diluted at 1:200(room temperature, 45min).
Immunohistochemical analysis of paraffin-embedded human liver cancer. 1, Antibody was diluted at 1:200(4° overnight). 2, Tris-EDTA,pH9.0 was used for antigen retrieval. 3,Secondary antibody was diluted at 1:200(room temperature, 45min).

 Manual
Manual